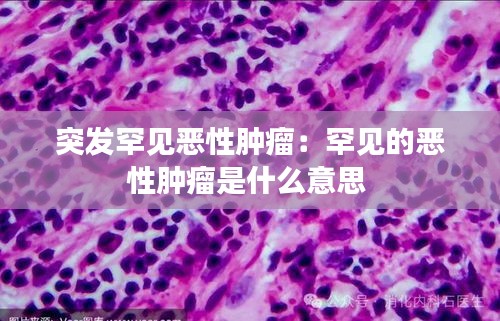

什么是突发罕见恶性肿瘤
恶性肿瘤,通常被称为癌症,是一种细胞不受控制生长和分裂的疾病。大多数恶性肿瘤都是常见的,如肺癌、乳腺癌和结直肠癌等。然而,有些恶性肿瘤属于罕见类型,它们在人群中的发病率极低。这些罕见恶性肿瘤可能由于基因突变、遗传因素或环境因素等多种原因引起,其症状、治疗和预后往往与常见恶性肿瘤有所不同。
罕见恶性肿瘤的特点
罕见恶性肿瘤具有以下特点:
发病率低:罕见恶性肿瘤的发病率通常低于1%,这意味着每年在特定人群中只有极少数人会被诊断出这种疾病。
症状不典型:由于罕见恶性肿瘤的病例数量较少,其症状可能不像常见恶性肿瘤那样明确,这可能导致诊断延误。
治疗选择有限:由于罕见恶性肿瘤的研究相对较少,治疗选择可能有限,且缺乏针对性的治疗方法。
预后复杂:罕见恶性肿瘤的预后因病例而异,有些患者可能预后较好,而有些患者则可能面临较高的死亡率。
常见罕见恶性肿瘤类型
以下是一些常见的罕见恶性肿瘤类型:
肉瘤:如横纹肌肉瘤、骨肉瘤、纤维肉瘤等。
神经内分泌肿瘤:如类癌、副神经节瘤等。
皮肤癌:如恶性黑色素瘤、皮肤鳞状细胞癌等。
生殖系统肿瘤:如卵巢癌、睾丸癌、宫颈癌等。
脑肿瘤:如垂体腺瘤、脑膜瘤等。
诊断与治疗挑战
由于罕见恶性肿瘤的罕见性,诊断和治疗都面临着诸多挑战:
诊断困难:罕见恶性肿瘤的症状可能与其他疾病相似,且缺乏特异性检查方法,导致诊断困难。
研究资源有限:由于病例数量少,罕见恶性肿瘤的研究资源相对有限,限制了新治疗方法的开发。
治疗选择有限:由于缺乏针对性的治疗方案,患者可能需要尝试多种治疗方法,包括手术、化疗、放疗等。
预后评估困难:由于病例数量少,难以准确评估罕见恶性肿瘤的预后。
患者支持与倡导
面对罕见恶性肿瘤的挑战,患者和家属需要寻求支持和倡导:
患者支持组织:加入罕见恶性肿瘤患者支持组织,与其他患者分享经验,获取信息和支持。
医学研究:支持罕见恶性肿瘤的研究,鼓励医学界关注这些疾病。
政策倡导:倡导政府和社会关注罕见恶性肿瘤,争取更多的研究和治疗资源。
提高公众意识:通过教育和宣传,提高公众对罕见恶性肿瘤的认识,减少误解和歧视。
结论
突发罕见恶性肿瘤给患者和家庭带来了巨大的挑战。尽管诊断和治疗仍然存在困难,但通过患者、家属、医疗专业人员和社会各界的共同努力,我们可以提高对这些疾病的认识,改善患者的预后。未来,随着医学研究的不断深入,我们有理由相信,罕见恶性肿瘤的治疗将取得更大的突破。
转载请注明来自中蚨科技,本文标题:《突发罕见恶性肿瘤:罕见的恶性肿瘤是什么意思 》

京ICP备16057535号-1
还没有评论,来说两句吧...